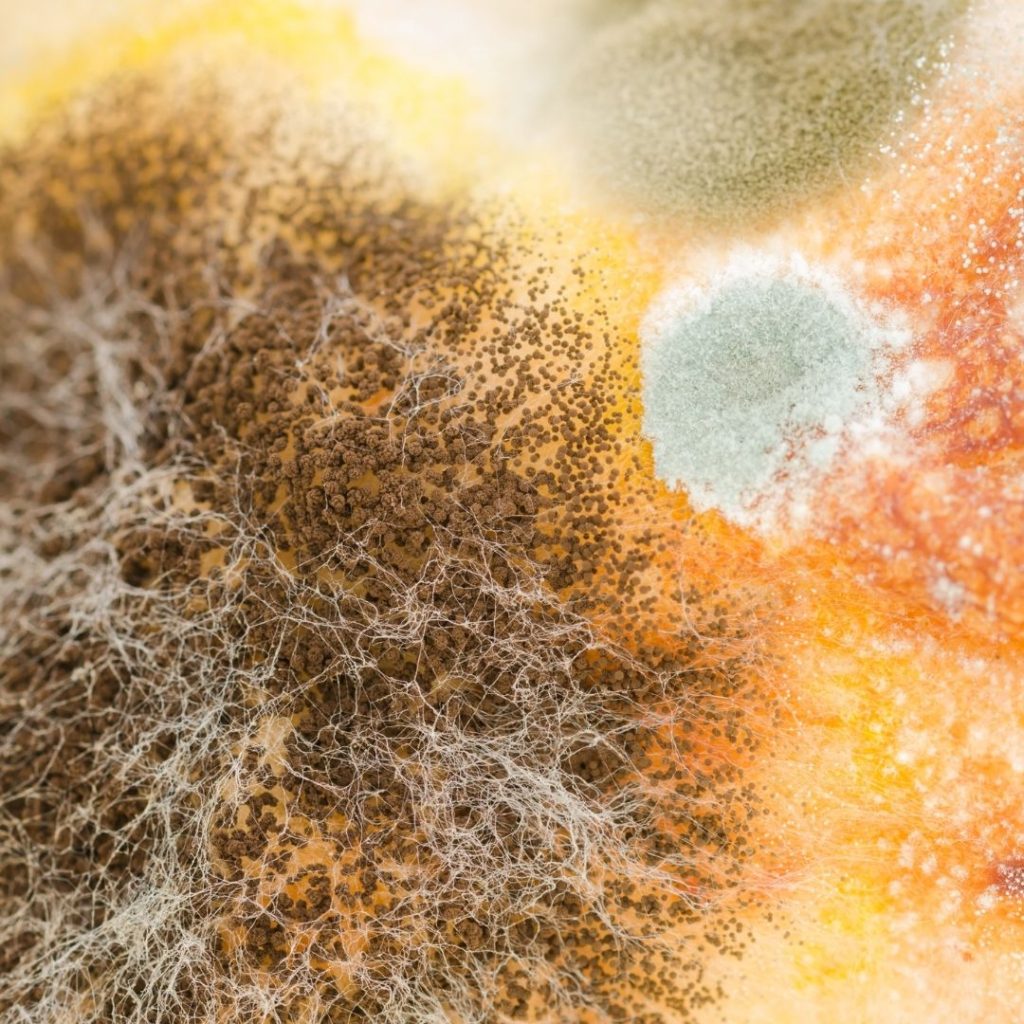

Acredito que todos já encontramos algum alimento mofado, não é mesmo?

Algumas situações que podem ocorrer facilmente:
– Uma fatia de pão mofada e as outras fatias com características “normais”.
– Frutas começando a formar a famosa “penugem” em uma ponta ou um dos lados.
– Requeijão aberto na geladeira, com mofo em alguns pontos.
– Bolos, queijos e outros alimentos.
E o que você fez?
Cortou a parte mofada e ingeriu o alimento ou jogou tudo no lixo?
Os mofos e/ou bolores, são espécies de fungos filamentosos que se desenvolvem em matéria orgânica e que possuem a capacidade de decompor a mesma. Podem ser encontrados em colorações azuladas, avermelhadas, esverdeadas ou esbranquiçadas.
Ao visualizarmos a alteração da característica a olho nu, significa que há uma grande quantidade presente no alimento, que pode alterar o sabor dos produtos, prejudicar a qualidade e liberar toxinas prejudiciais à nossa saúde.
Alguns fungos produzem substâncias tóxicas chamadas micotoxinas. Um exemplo é a aflatoxina, que pode ser encontrada no amendoim, milho e outros grãos, devido a condições inadequadas de secagem e armazenamento, o que pode provocar o desenvolvimento de doenças pelo consumo prolongado. A toxina pode ainda causar sintomas agudos, causando intoxicações graves, levando à morte.
O que diz o Departamento Americano de Agricultura, Segurança Alimentar e Inspeção
Em um informativo à população, o Departamento Americano de Agricultura, Segurança Alimentar e Inspeção (USDA na sigla em inglês) recomenda comprar quantidades pequenas de alimentos e consumi-los rapidamente para evitar que fungos se desenvolvam. Mas no caso de alimentos com um aspecto geral pode ser difícil não ceder à tentação de apenas cortar fora e descartar a parte em que o fungo está mais visível, e comer o resto.
Segundo o serviço americano, há apenas alguns casos em que essa estratégia é segura, normalmente com alimentos mais rígidos. Alimentos macios e com maior teor de água facilitam que o mofo se espalhe por todo ele.
A recomendação é descartar a alimento mofado para evitar possíveis reações alérgicas, diarreia e vômitos.
Meus contatos:
– WhatsApp: (54) 9 9174-4490
– Instagram: @crispigozzo
– E-mail: crispigozzo@gmail.com
Deixe seu feedback